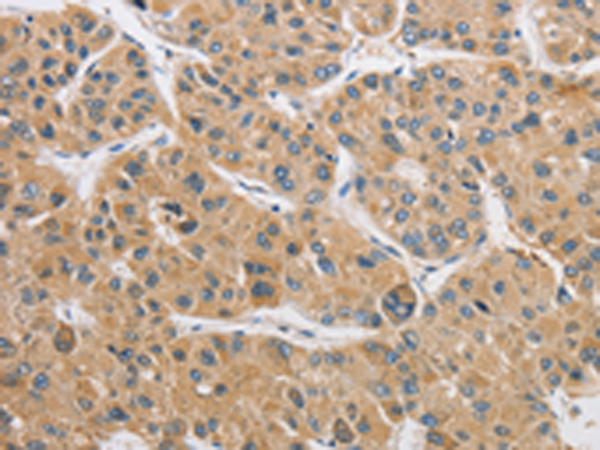

-
分类: 科研抗体货号: P00958别名: ARHI; NOEY2应用: IHC反应种属: Human
-
分类: 科研抗体货号: P00897别名: ALP应用: WB,IHC反应种属: Human, Mouse
-
分类: 科研抗体货号: P00840别名: ACATE2; CGI-16; MTACT48; MT-ACT48应用: WB,IHC反应种属: Human, Mouse
-
分类: 科研抗体货号: P00954别名: P60; TIM; GEF5; TIM1应用: WB,IHC反应种属: Human
-
分类: 科研抗体货号: P00896别名: ARCI3; E-LOX; eLOX3; eLOX-3应用: WB反应种属: Human, Mouse, Rat
-
分类: 科研抗体货号: P00830别名: BCOX; BRCOX; THCCox; BRCACOX应用: WB,IHC反应种属: Human, Mouse
-
分类: 科研抗体货号: P00952别名: BM046应用: WB,IHC反应种属: Human, Mouse, Rat
-
分类: 科研抗体货号: P00895别名: ADAS; ADPS; ADAP-S; ADHAPS; ALDHPSY应用: WB,IHC反应种属: Human, Mouse, Rat
-
分类: 科研抗体货号: P00921别名: AngX; CDT6; dJ647M16.1; RP4-647M16.2应用: IHC反应种属: Human, Mouse, Rat
-
分类: 科研抗体货号: P00942别名: HPP1; ula-1; APPBP1; A-116A10.1应用: IHC反应种属: Human, Mouse, Rat

鄂公网安备42018502007531号
鄂公网安备42018502007531号

